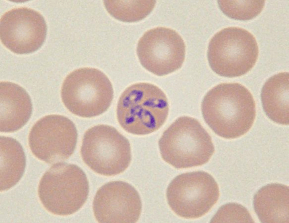
Red Blood Cell Pathology
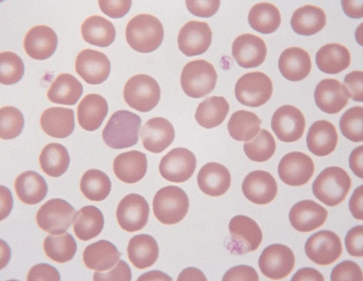
Red Blood Cell Physiology

“MARVELLOUS WORK HELPING STUDENTS RECALL AND LEARN/ UNDERSTAND BETTER & ON FINGER TIPS”
Shehla, Associate Professor - University of Veterinary and Animal Sciences, Lahore-Pakistan
“I thought it was really brilliant! Thank you.”
Andrew, Professor - University of Pretoria
“Excellent refresher of key concepts, loved it!”
Leigh, Veterinary Student - Colorado State University
“Really enjoyed this quiz! Very informative! These revision card packs are a
great idea!”
Brogan, Veterinary Student - University of Surrey
“This was great! The terms and definitions were all very helpful - I really like the visual questions for identification too!”
Emily, Veterinary Student - Virginia Tech
“Very much enjoying the flashcards! Great that you have so many pictures, really great practice”
Brogan, Veterinary Student - University of Surrey
“It was very useful and easy to use! I like the fact that the answers are just behind the question.”
Alice, Veterinary Student - VetAgro Sup, France
“This set is nice and informative. It was very fun and interesting thing to do. Nice additional links for further reading.”
Weronika, Veterinary Student - University of Agriculture in Krakow
“The platform is great and most of the questions are very interesting and can be answered from veterinary students as well, not only by veterinarians!!”
Themistoklis, Veterinary Student - AUTh, Greece
“Great! really happy with these flashcard courses, thank you”
Iina-Lotta, Veterinary Student - University of Liverpool
“Very helpful! These cards are really helping me revise for my finals!”
Matthew, Veterinary Student - University of Pretoria
“these are super helpful”
Rebecca, Veterinary Student - University of Pennsylvania
“This is really cool!”
Joseph, Veterinary Student - Mississippi State University
“So far, so good! Interesting mix of questions.”
Sean, Veterinary Student - University College Dublin
“So far so good! This is very helpful and I'm glad you have these now.”
Soraya, Veterinary Student - Western University
“Great questions! These were awesome (urinalysis) and got me reviewing my crystals and differentials for different urine sediment presentations!!! :D :D :D
Please make more flashcards for more topics…” See more
Meredith, Veterinary Student - University of Guelph
“These cards have been very good! I would love to have more of them!”
Laura, Veterinary Student - Universidade de Santiago de Compostela
“loving these thank you!”
Dr. Luke, VIN Member
“So far so good. Enjoying the visuals and information attached.”
Alejandro, Veterinary Student - Colorado State University
“very interesting!”
Sophie, Veterinary Student - University of Gent
“I like it very much”
Marília, Veterinary Student - Federal University of Paraná, Brazil
“Great work guys!”
Mona, Veterinary Student - Faculty of Veterinary Medicine, Cairo University
“Fantastic, I loved it.”
Ahmed, Veterinary Student - University of Sao Paulo, Brazil
“I love it! It was really good!”
Maria, Veterinary Student - University of Utrecht
“These are a great study tool!”
Nevada, Veterinary Student - University of Sydney
“Love it! It is a good basic refresher (I am a second year just now learning this material) I love examples, so the more pictures the better”
Brandon, Veterinary Student - NC State University
“Great! These are great supplement to my toxicology course.”
Amy, Veterinary Student - Western University
“Love them! I'm a second year student taking Clinical Pathology and these are so so helpful! Thank you so much!!”
Lauren, Veterinary Student - Cornell University
“You guys are the best! I'm loving the new flashcards!”
Charbel, Veterinary Student - Lebanese University
“Amazing!! I am 2nd year UF student about to take our neuro final this week and these cases are reviewing all of the core concepts we went over. So helpful with putting what Ive learned into practice …” See more
Taelor, Veterinary Student - University of Florida
“I am enjoying the flashcards and I am happy to have learned about a few things I've never seen before.”
Madison, Veterinary Student - Washington State University
“I am very happy that you are facilitating these flashcards. Very helpful, thank you!”
Annika, Veterinary Student - Utrecht University
“This is a great resource and I'm really enjoying seeing actual presentations instead of what the textbook says should happen!”
Tamara, Veterinarian
“Great, thank you! Looking forward to working my way through the other flashcards. It is really helpful to be able to see what the signs we are learning about from lectures and textbooks actually look…” See more
Alisha, Veterinary Student - University of Liverpool
“There are lots of information that I haven't been taught at school yet so this is good for expanding my knowledge. ;)”
Punyisa, Veterinary student - Faculty of Agriculture Kamphaeng Saen, Thailand
“Great cases! Concise descriptions. No pressure if we get things wrong or have no clue. Nice confidence builder for neuro.”
Jeremy, VIN Member
“These flashcards are amazing revision resources!!”
Sigourney, Veterinary Student - University of Surrey
“Love these flashcards!”
Ellen, Veterinary Student - University of Wisconsin-Madison
“Very useful and easy to use! Love it so far!”
Irene, Veterinary Student - Universidad de Zaragoza
“Superb!”
Sophie, Veterinary Student - University of Ghent
“These are great! I find that they are helping a lot.”
Martin, Veterinary Student - Mississippi State University
“Really amazing!”
Cheyenne, Veterinary Student - University of Surrey
“:) Grateful to have this set of flashcards.”
Oleg, Veterinary Student - University of Wisconsin-Madison
“Incredibly helpful, thank you.”
Valerie, Veterinary Student - Long Island University
“Great; very helpful and clear, pointed questions”
Tiffany, University of Guelph
“Very good :)”
Katarina, Veterinary Student - Ludwig-Maximilians-University Munich
“awesome!”
Ibrahim, Veterinary Student - University of Istanbul
“I love these flash cards and more than that the link that they come with.”
Matin, Veterinarian
“Loving the videos!”
Adrianna, Veterinary Student - University of Saskatchewan
“Excellent. Very informative.”
Mark, Veterinarian
“Good! helping me study for an exam on friday :)”
Hannah, Veterinary student - Washington State University
“The flashcards are great!”
Katherine, Veterinarian
“Pretty awesome!”
Thomas, Veterinarian
“This is great review!”
Cody, Veterinary student - Oklahoma State University
“It is a very nice study set that allows me to see the gaps in my study, however daunting that may be.”
Alesha, Veterinary student- James Cook University
“I was enjoying the cards and learning a lot. It was really a great refresher and the first time I have used the flashcards. Thanks!”
Michael, Veterinarian
“It was brilliant! Super refresher course.”
Olivia, Veterinary Student - University of Melbourne
“These are amazing”
Caileigh, Veterinary Student - University of Calgary
“I really like these, they remind me of test questions that my actual faculty would write!”
Amy, Veterinary student - Western University
“Great , I love the flashcards”
Keli, Veterinarian
“This was so helpful, got to apply my knowledge”
Sabelisiwe, Veterinarian
“I like it! It's simple and step by step.”
Mischa, Veterinary Student - Texas A&M College of Veterinary Medicine & Biomedical Sciences
“Great refresher/summary. Thanks”
Jane, Veterinarian
“It was really useful! Thank you :)”
Laura, Veterinarian - Intern
“great exercise!!!”
Camila, Veterinary Student - Universidad Autónoma de Baja Califórnia
“I absolutely adored them.”
Maria, Veterinary Student - Instituto de Ciências Biomédicas Abel Salazar - Sigarra
“These are a mixture of clinically relevant and "oh my gosh I used to have that memorized I'm glad someone else knows that". I'm enjoying it!”
Melissa, Veterinarian
“It's awesome!! thank you!”
Anneke, Veterinary student - Facultad de Medicina Veterinaria y Zootecnia, Mexico
“Wonderful, I learned a lot!”
Alexandra, Veterinarian
“very informative and easy to keep up!”
Ashlee, Veterinarian
“Very informative! Thank you for this content.”
Bruna, Veterinary Student - Universidade Estadual do Norte Fluminense (UENF) - Brazil
“Very user-friendly!”
Karina, Veterinary Student - Universitas Padjadjaran, Indonesia
“I love that each case is talked through and explained.”
Rachael, Veterinary Student - Auburn University
“Love this!”
Alexis, Veterinary Student - Massey University
“Very good! Such nice clear images. Appreciate the hard work obviously put into these”
Hailey, Veterinary Student - Auburn University
“Really enjoyed it. Learned a lot. Excellent way of sharpening up my avian anatomy”
Mark, Veternarian
“Great course. Thanks!”
Selena, Veterinarian
“I like the cards! great topics”
Patricia, Veterinary Student - University of Pennsylvania
“Helped me figure out the topics I need to focus on. Liked it!”
Vani, VIN Member
“Perfect! Very helpful and interactive.”
Thao, Veterinary Student
“It’s been a pleasant surprise so far. It was informative and educative. It was fun too.”
Ifeoluwa, Veterinary Student - University of Ibadan
“Good study session!”
Danielle, Veterinary Student - Oregon State University
“The best veterinary flashcard resource! Not written by students and a good mix of pictures and written cards.”
Laila, University of Liverpool